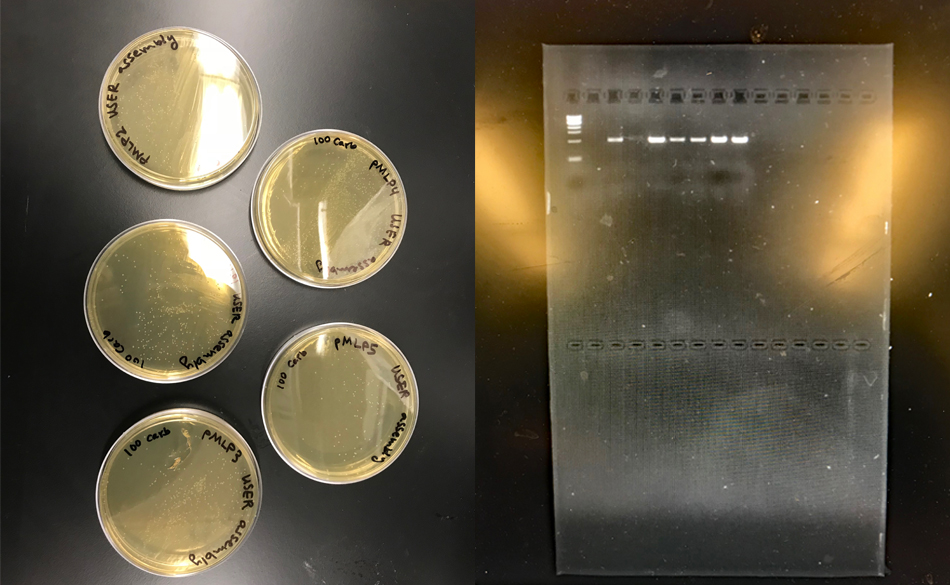

Fieldwork
This listing expired on November 1, 2020. Please contact info@ifrglobal.org for any updated information.

Location: Mo'orea, Moorea-Maiao, French Polynesia
Season: June 21, 2020 to July 18, 2020
Application Deadline: April 3, 2020
Deadline Type: Rolling
Website: https://ifrglobal.org/program/french-polynesia-moorea/
Program Type:
Field School
RPA Certified:
No
Affiliation:
University of California, San Diego, Connecticut College, Institute for Field Research
Project Director:
Dr. Keolu Fox
Project Description:
Currently eighty-eight percent of large scale screens of human genetic variation and ninety-five percent of clinical trials exclusively feature individuals of European ancestry. As a result the future of biomedicine (i.e. personalized, predictive, and preventative medicine) does not include underrepresented minorities (including Indigenous peoples). This bias and systematic lack of engagement of underrepresented minorities/ Indigenous people in both clinical trials and genome studies is partially the result of a history of distrust. Through the Indigenous Futures Lab (IFL) Field School we will train the next-generation of global health professionals to imagine, promote, and sustain a future where Indigenous people are partners in and not subjects of genetic research.
The IFL Field School is a medical anthropology/global health -based field school that utilizes community-based participatory research methods (CBPR) to train student participants to engage Indigenous communities using culturally sustainable methods, and co-develop novel hypothesis related to Indigenous health. In partnership with the Moruroa e tatou association, the Atitia Center and the University of California Berkeley Gump Research Station (all located in Mo’orea, Tahiti), we have established a field school lead by an interdisciplinary team of Indigenous/Pasifika scholars. Our goal is to recruit Polynesian community members as participants in a long-term study to identify the impact of colonialism on the human genome.
Period(s) of Occupation: Ethnography, Indigenous Genomics
Project Size: 1-24 participants
Minimum Length of Stay for Volunteers: Participants must stay entire duration of the field school.
Minimum Age: 18
Experience Required: No experience required.
Room and Board Arrangements:
Students and instructors will stay in the UC Berkley Gump Station Dorms, a multipurpose facility and the Atitia community center located next to the UC Berkeley Gump Research Station. In this community center students will share unfurnished private rooms and should bring sleeping bags, camping mats, and mosquito nets.
Both the UC Gump research station and the Atitia Center have kitchen facilities and all meals will cooked by committee with students and staff organizing a shared cooking schedule. Any allergies will be strictly monitored and dietary restrictions such as vegetarianism will be accommodated.
Academic Credit:
8 Semester Credit Units (12 quarter ) offered by Connecticut College. Tuition is $4,300.
Institute for Field Research
2999 Overland Ave.
Los Angeles
CA
90064
United States
Phone: 8778394374
The AIA is North America's largest and oldest nonprofit organization dedicated to archaeology. The Institute advances awareness, education, fieldwork, preservation, publication, and research of archaeological sites and cultural heritage throughout the world. Your contribution makes a difference.